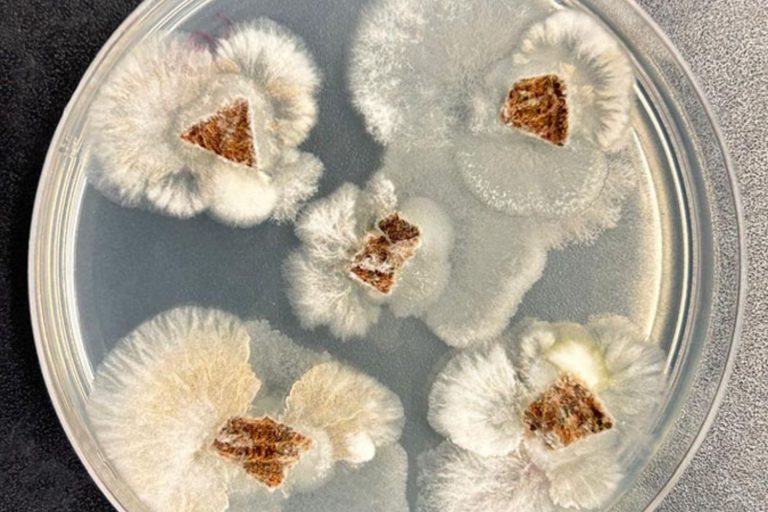
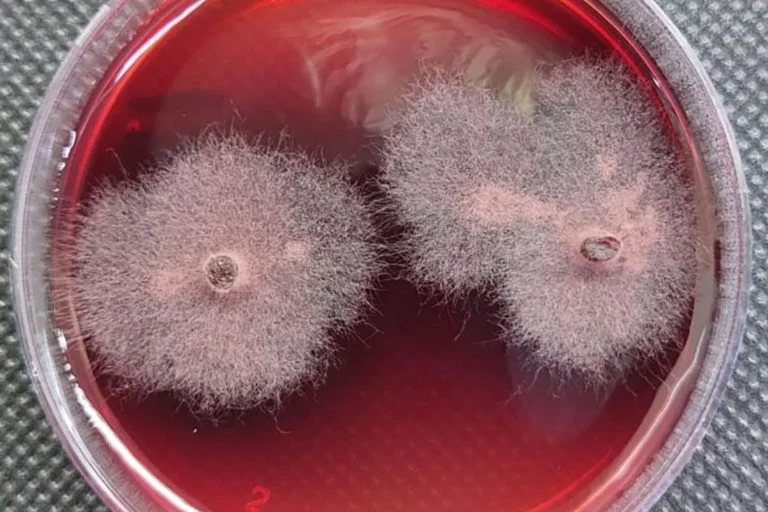

Debora Barreto/Embrapa
Uma equipe de pesquisadores da Universidade Federal de Minas Gerais (UFMG), da Embrapa Meio Ambiente e do Departamento de Agricultura dos Estados Unidos (USDA) fez uma descoberta promissora: uma molécula inédita com potencial revolucionário para o setor de bioinsumos agrícolas. Este segmento está em rápida expansão global, prevendo-se que possa alcançar US$ 877 bilhões até 2035.
O composto, conhecido temporariamente como “composto 2”, demonstrou eficácia superior a herbicidas sintéticos, como glifosato e clomazona, em testes laboratoriais.
A pesquisa evidencia a riqueza da biodiversidade brasileira como fonte vital de inovações nas indústrias de agricultura, biotecnologia e química fina. Além disso, ela se alinha à necessidade crescente por soluções mais sustentáveis e eficazes, reduzindo os danos associados ao uso de defensivos químicos convencionais.
O Nascimento da Descoberta: Segredos dos Fungos
A jornada para a descoberta começou com o isolamento de um fungo endofítico, um organismo que habita plantas sem causar danos e que, muitas vezes, fortalece suas defesas naturais. Esses fungos são conhecidos por produzirem metabólitos bioativos, que são substâncias químicas com atividades biológicas, como a inibição do crescimento de outras plantas ou a proteção contra pragas e patógenos.
O fungo, coletado em 2017 a partir de uma planta medicinal do gênero Piper no Parque Estadual da Floresta do Rio Doce (MG), foi cuidadosamente isolado e preservado para estudos posteriores. A análise revelou que pertence ao gênero Fusarium, uma família bastante comum e diversificada. Mesmo sem uma identificação precisa da espécie, a equipe se dedicou a investigar os compostos produzidos pelo microrganismo.
Esse tipo de pesquisa está se tornando uma tendência global, que busca novas moléculas em microrganismos associados a plantas, capazes de substituir ou complementar defensivos agrícolas tradicionais.
Testes Incríveis: Superando Expectativas
Debora Barreto/Embrapa
Fungos endofíticos emergindo do tecido foliar
A equipe isolou e extraiu três substâncias do fungo, incluindo o composto 2, uma molécula inédita até então. Nos testes realizados com sementes de alface e um tipo de gramínea, o composto 2 inibiu a germinação das plantas em doses relativamente baixas.
Os resultados foram ainda mais impressionantes quando compararam o desempenho do composto a herbicidas conhecidos. Medido pelo indicador IC50, que avalia a quantidade necessária para reduzir em 50% o crescimento de uma planta, o composto 2 mostrou valores inferiores aos encontrados para glifosato e clomazona, evidenciando sua potência superior.
Da mesma forma, testes com patógenos agrícolas mostraram que o composto 2, ao combater o fungo Colletotrichum fragariae, que afeta plantações de morangos, apresentou uma inibição mais robusta do que substâncias naturais referência nesse tipo de teste.
De acordo com a pesquisadora Sonia Queiroz, da Embrapa Meio Ambiente, a nova molécula pode ser aplicada não apenas como herbicida, mas também como antifúngico, ampliando assim seu apelo comercial e tecnológico.
A Importância Econômica e Agronômica da Descoberta
A agricultura mundial está vivendo um período de transformação. Desde os anos 40, os defensivos sintéticos têm sido fundamentais para aumentar a produtividade alimentar. No entanto, o uso excessivo trouxe desafios, como a resistência das pragas e critérios regulatórios mais rigorosos. Agora, o setor busca alternativas que garantam a produtividade sem aumentar os riscos ambientais.
Nesse contexto, bioinsumos como o composto 2 se destacam. Eles podem diminuir a dependência de produtos químicos tradicionais, oferecer novas estratégias contra pragas resistentes e ajudar a construir cadeias agrícolas mais sustentáveis, algo que é cada vez mais valorizado por consumidores, investidores e mercados internacionais.
Para o Brasil, essa descoberta também representa um reforço do potencial econômico de sua biodiversidade, funcionando como um motor para inovações. Países que conseguem converter sua riqueza biológica em propriedade intelectual, como moléculas e tecnologias, conquistam vantagens competitivas em mercados globais de alto valor.
O professor Luiz Henrique Rosa, da UFMG, destacou que este estudo é “o início de uma trajetória que pode levar ao desenvolvimento de novos herbicidas e fungicidas comerciais”, contanto que os próximos passos confirmem a segurança e eficácia da nova molécula.
Do Laboratório ao Campo: O Caminho para a Comercialização
Debora Barreto/Embrapa
Fungos endofíticos
Apesar dos resultados promissores, transformar uma nova molécula em um bioinsumo comercial é um desafio complexo. Os pesquisadores agora focarão em estudos de segurança, avaliação dos mecanismos de ação e testes adicionais em condições reais de cultivo. Também será necessário desenvolver formulações que sejam estáveis, escaláveis e compatíveis com as aplicações agrícolas.
Outro aspecto interessante observado foi o fenômeno conhecido como “hormese”, onde doses baixas de certas substâncias podem estimular o crescimento das plantas. Isso sugere que o composto 2 tem potencial para ser utilizado também como bioestimulante, dependendo da dosagem e da cultura agrícola.
A equipe resume o atual momento como uma fronteira científica em expansão, onde microrganismos invisíveis, muitos deles protegidos nas ricas reservas naturais do Brasil, têm a capacidade de se transformar, nos próximos anos, em ingredientes valiosos para um mercado global em transformação.




